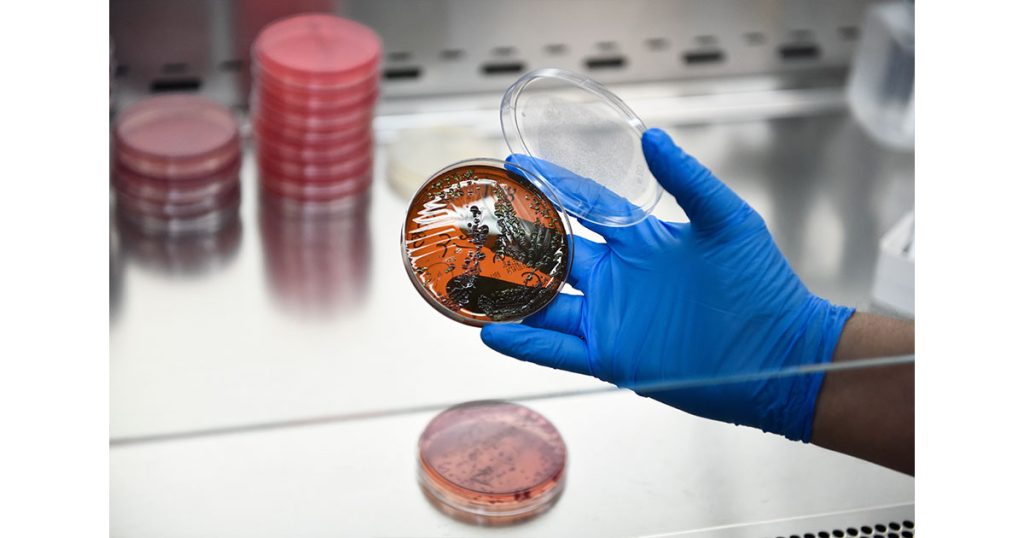
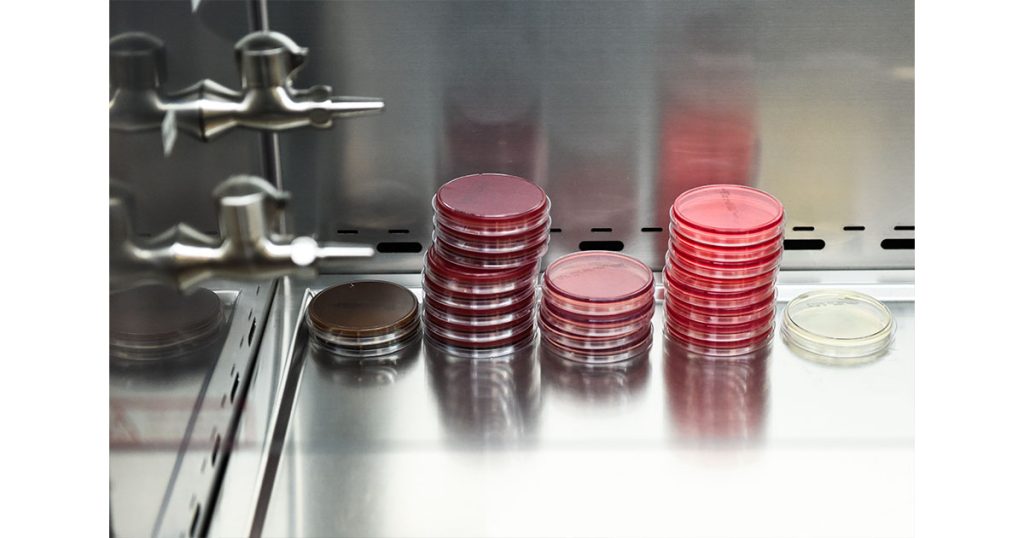

¿Sabías que el Centro Médico de Especialidades (CME) cuenta con un área de biología molecular?
Esta rama de la biología, tiene como objetivo estudiar los procesos que se desarrollan en los seres vivos desde un punto de vista molecular.
En la biología molecular se realizan estudios con diversas técnicas como el PCR (reacción en cadena de la polimerasa), el cual busca DNA o RNA de algún patógeno, ya sea un virus, bacteria u hongo que es difícil de aislar en los tradicionales medios de cultivo.

“Puede detectar cantidades muy pequeñitas, podemos hacer un diagnóstico más acertado”, comenta el QBP Diego Arreola, encargado del laboratorio de patología clínica del CME.
En el área de la biología molecular existen diversos paneles, los cuales son muy útiles para que los médicos puedan dar un diagnóstico acertado y en menor tiempo a sus pacientes.
Entre ellos, se encuentra el que detecta la presencia de patógenos que se transmiten por medio de la picadura de una garrapata como la borrelia o rickettsia.
“A veces cuando una persona se contagia con estas bacterias es algo difícil de diagnosticar para el médico porque los síntomas pueden ser vagos como la fiebre, un salpullido o dolor de cabeza intenso”, menciona.
Si se sospecha de la picadura de la garrapata, por medio del PCR se puede determinar su presencia en horas y evitar que la enfermedad progrese.
Otro panel se enfoca en las enfermedades de transmisión sexual y entre los patógenos se incluyen las bacterias neisseria que causa la gonorrea, la micoplasma y la clamidia, siendo esta última quizá la causante del mayor número de casos.

“El problema con esta bacteria es que en muchas ocasiones pasa desapercibida, la persona se contagia y no tiene síntomas o casualmente tiene un poquito de ardor al orinar, si dejamos progresar y por ejemplo, la mujer está embarazada, puede contagiarse el bebé; también se ha observado que se relaciona con abortos o bebés prematuros e incluso, con infertilidad en hombres y mujeres”, señala.
A través de la biología molecular también se pueden identificar patógenos que causan meningitis o encefalitis, en las que resulta crítico el tiempo del diagnóstico para la salud y economía de los pacientes.

“El hospital trata de tener los mejores recursos tecnológicos en todas las áreas, incluidos los servicios auxiliares de diagnóstico que son imagenología y el laboratorio clínico, así como personal capacitado para realizar los estudios”, finaliza.
CME se une a la lucha contra el cáncer de mama
El hospital promueve la prevención y detección oportuna con la participación de directivos, personal y alumnos
Por Marisol Rodríguez
GALERÍA: Corren por su salud celebrando al CME
Cientos de corredores juarenses participaron en la carrera por el 76 aniversario del Centro Médico de Especialidades realizada este domingo
Por José Estrada
Alista CME su 15 carrera pedestre ‘Corre por tu salud’
La competencia forma parte de los festejos de su 76 aniversario; no te la pierdas este domingo 20 de julio
Por Redacción
Presenta CME su Departamento de Investigación
Su objetivo es ser un referente en avances científicos y generar un impacto en la salud de la comunidad
Por Marisol Rodríguez